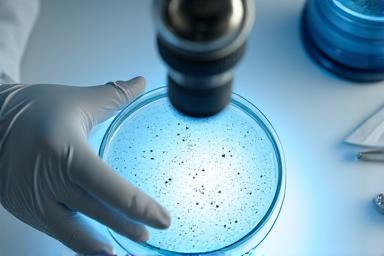

Izglītība ir spēcīgākais rīks vides aizsardzībā
Mēs to padarām saistošu un praktisku, iedvesmojot rūpes par jūras vidi.
Rezervējiet programmu tagadMūsu ietekme skaitļos
"Viļņu Bites" ir uzticams partneris izglītībā, kas rada redzamus rezultātus.
5000+
dalībnieki mūsu izglītības programmās
25+
sadarbības skolas un universitātes
95%
pozitīvas atsauksmes no dalībniekiem
Vispusīgas jūras izglītības programmas visiem vecumiem

Pirmsskolas un sākumskolas programmas
Mēs piedāvājam aizraujošas un interaktīvas nodarbības, kas iepazīstina pašus jaunākos ar Baltijas jūras brīnumiem, tās iemītniekiem un vides aizsardzības pamatiem, izmantojot spēles un praktiskas aktivitātes.
- Aizraujošas pasakas par jūras dzīvniekiem
- Smilšu un ūdens eksperimenti
- Krāsošana un radošās darbnīcas ar jūras tematiku

Pusaudžu un vidusskolas izglītojošie kursi
Analītiskas un datu vadītas programmas, kas ļauj jauniešiem iedziļināties aktuālās jūras vides problēmās, iemācīties pētniecības metodes un izprast globālo kontekstu.
- Datu analīze un zinātniskā prezentācija
- Diskusijas par ilgtspējīgu attīstību
- Field trips uz jūras piekrasti un ostām

Pieaugušo izglītība un korporatīvās apmācības
Specializēti semināri un meistarklases uzņēmumiem un indivīdiem, kuri vēlas padziļināt izpratni par jūras ekosistēmām, ilgtspējīga biznesa praksi un iegūt jaunas vides pārvaldības prasmes.
- Vides audits un ilgtspējas stratēģijas
- Jūras piesārņojuma mazināšanas risinājumi
- CSR iniciatīvu plānošana
Praktisko meistarklašu katalogs
Mikroplastmasas detektīvi
Praktiska laboratorijas nodarbība par mikroplastmasas identificēšanu un ietekmi uz jūras vidi.
Grūtības pakāpe: Vidēja Pieteikties
Jūras dzīvnieku pasaule
Iepazīšanās ar Baltijas jūras bioloģisko daudzveidību un tās aizsardzības nozīmi.
Grūtības pakāpe: Zema Pieteikties
Klimata izmaiņu ietekme
Datu zinātnes pieeja klimata pārmaiņu ietekmes izpratnei uz jūras ekosistēmām.
Grūtības pakāpe: Augsta Pieteikties
Ilgtspējīga dzīvesveida izvēles
Praktiski padomi un aktivitātes, kā katrs var veicināt jūras vides veselību.
Grūtības pakāpe: Zema PieteiktiesTiešsaistes mācību platforma un resursi

Izbaudiet mācības ar modernām tehnoloģijām
Mūsu tiešsaistes platforma nodrošina pieeju padziļinātiem e-learning moduļiem, virtuālām ekskursijām un spēļu elementiem, lai jūras pētniecība kļūtu pieejama ikvienam.
- Interaktīvi e-learning moduļi
- VR tūres pa zemūdens pasauli
- Gamifikācijas elementi un progresa izsekošana
- Bezmaksas resursu bibliotēka skolotājiem
Sadarbības programmas skolām un universitātēm
Skolu apmeklējumi un lekcijas
Piedāvājam regulārus apmeklējumus ģeogrāfijas un bioloģijas stundās, papildinot mācību saturu ar praktiskiem piemēriem un pētniecības metodēm.
- Praktiskas demonstrācijas klasē
- Datu analīzes pamatprincipi
Ekskursijas un lauka pētījumi
Organizējam izglītojošas ekskursijas uz mūsu pētniecības objektiem un Baltijas jūras piekrasti, lai skolēni varētu novērot un piedalīties reālos pētījumos.
- Ekskursijas uz pētniecības kuģi
- Putnu un zivju novērojumi dabā
Pedagogu profesionālā pilnveide
Piedāvājam specializētus kursus skolotājiem, lai paplašinātu viņu zināšanas par jūras ekoloģiju un integrētu jaunākos pētījumus mācību programmās.
- Jaunas mācību metodes
- Kvalifikācijas celšanas sertifikāti
Kopīgi pētniecības projekti
Sadarbība ar studentiem un pasniedzējiem, īstenojot kopīgus pētniecības projektus, kas veicina zinātnisko inovāciju un jauno pētnieku attīstību.
- Inovatīvas pētniecības idejas
- Mentoru atbalsts un resursi
Korporatīvās vides apmācības uzņēmumiem

Mūsu pielāgotās apmācību programmas palīdz uzņēmumiem ne tikai izpildīt vides prasības, bet arī integrēt ilgtspējas principus savā korporatīvajā kultūrā, veidojot atbildīgu un zaļu zīmolu.
- CSR stratēģiju izstrāde
- Darbinieku ilgtspējas apmācības
- Vides pārvaldības sistēmu ieviešana
- Team building aktivitātes dabā
Publisko pasākumu un lekciju kalendārs
Ikmēneša publiskā lekcija: Baltijas jūras zivis
2024. gada 15. oktobris, plkst. 18:00
Lielā iela 14, Rīga
Izpētīsim Baltijas jūras zivju sugu daudzveidību, migrācijas ceļus un to saglabāšanas pasākumus.
PieteiktiesRudens pludmales tīrīšanas talka
2024. gada 26. oktobris, plkst. 10:00
Jūrmalas pludmale, Dubulti
Kopīgiem spēkiem sakopsim piekrasti! Visi laipni aicināti.
PieteiktiesZinātnes diena: Zemūdens droni
2024. gada 9. novembris, plkst. 11:00
Rīgas Tehniskā Universitāte
Iepazīsim jaunākās tehnoloģijas jūras pētniecībā – zemūdens dronu lietojumu un iespējas.
PieteiktiesMūsu izglītības programmu ietekme un atsauksmes
Ko saka mūsu partneri un dalībnieki
"Viļņu Bites programmas mainīja mūsu skolēnu izpratni par Baltijas jūru. Praktiskās nodarbības un pētnieku iesaiste bija nenovērtējama pieredze, kas iedvesmoja daudzus izvēlēties vides zinātni kā nākotnes karjeru."
"Korporatīvās apmācības ļāva mūsu komandai dziļāk ieskatīties ilgtspējīgas darbības principos. Tagad aktīvi ieviešam jaunas "zaļās" iniciatīvas, kas samazina mūsu uzņēmuma ekoloģisko pēdu."

Sazinieties ar mums, lai rezervētu programmu!
Mēs esam gatavi pielāgot programmas jūsu vajadzībām. Aizpildiet zemāk esošo veidlapu vai zvaniet mums.
SazinātiesVai zvaniet: +371 67 221 543